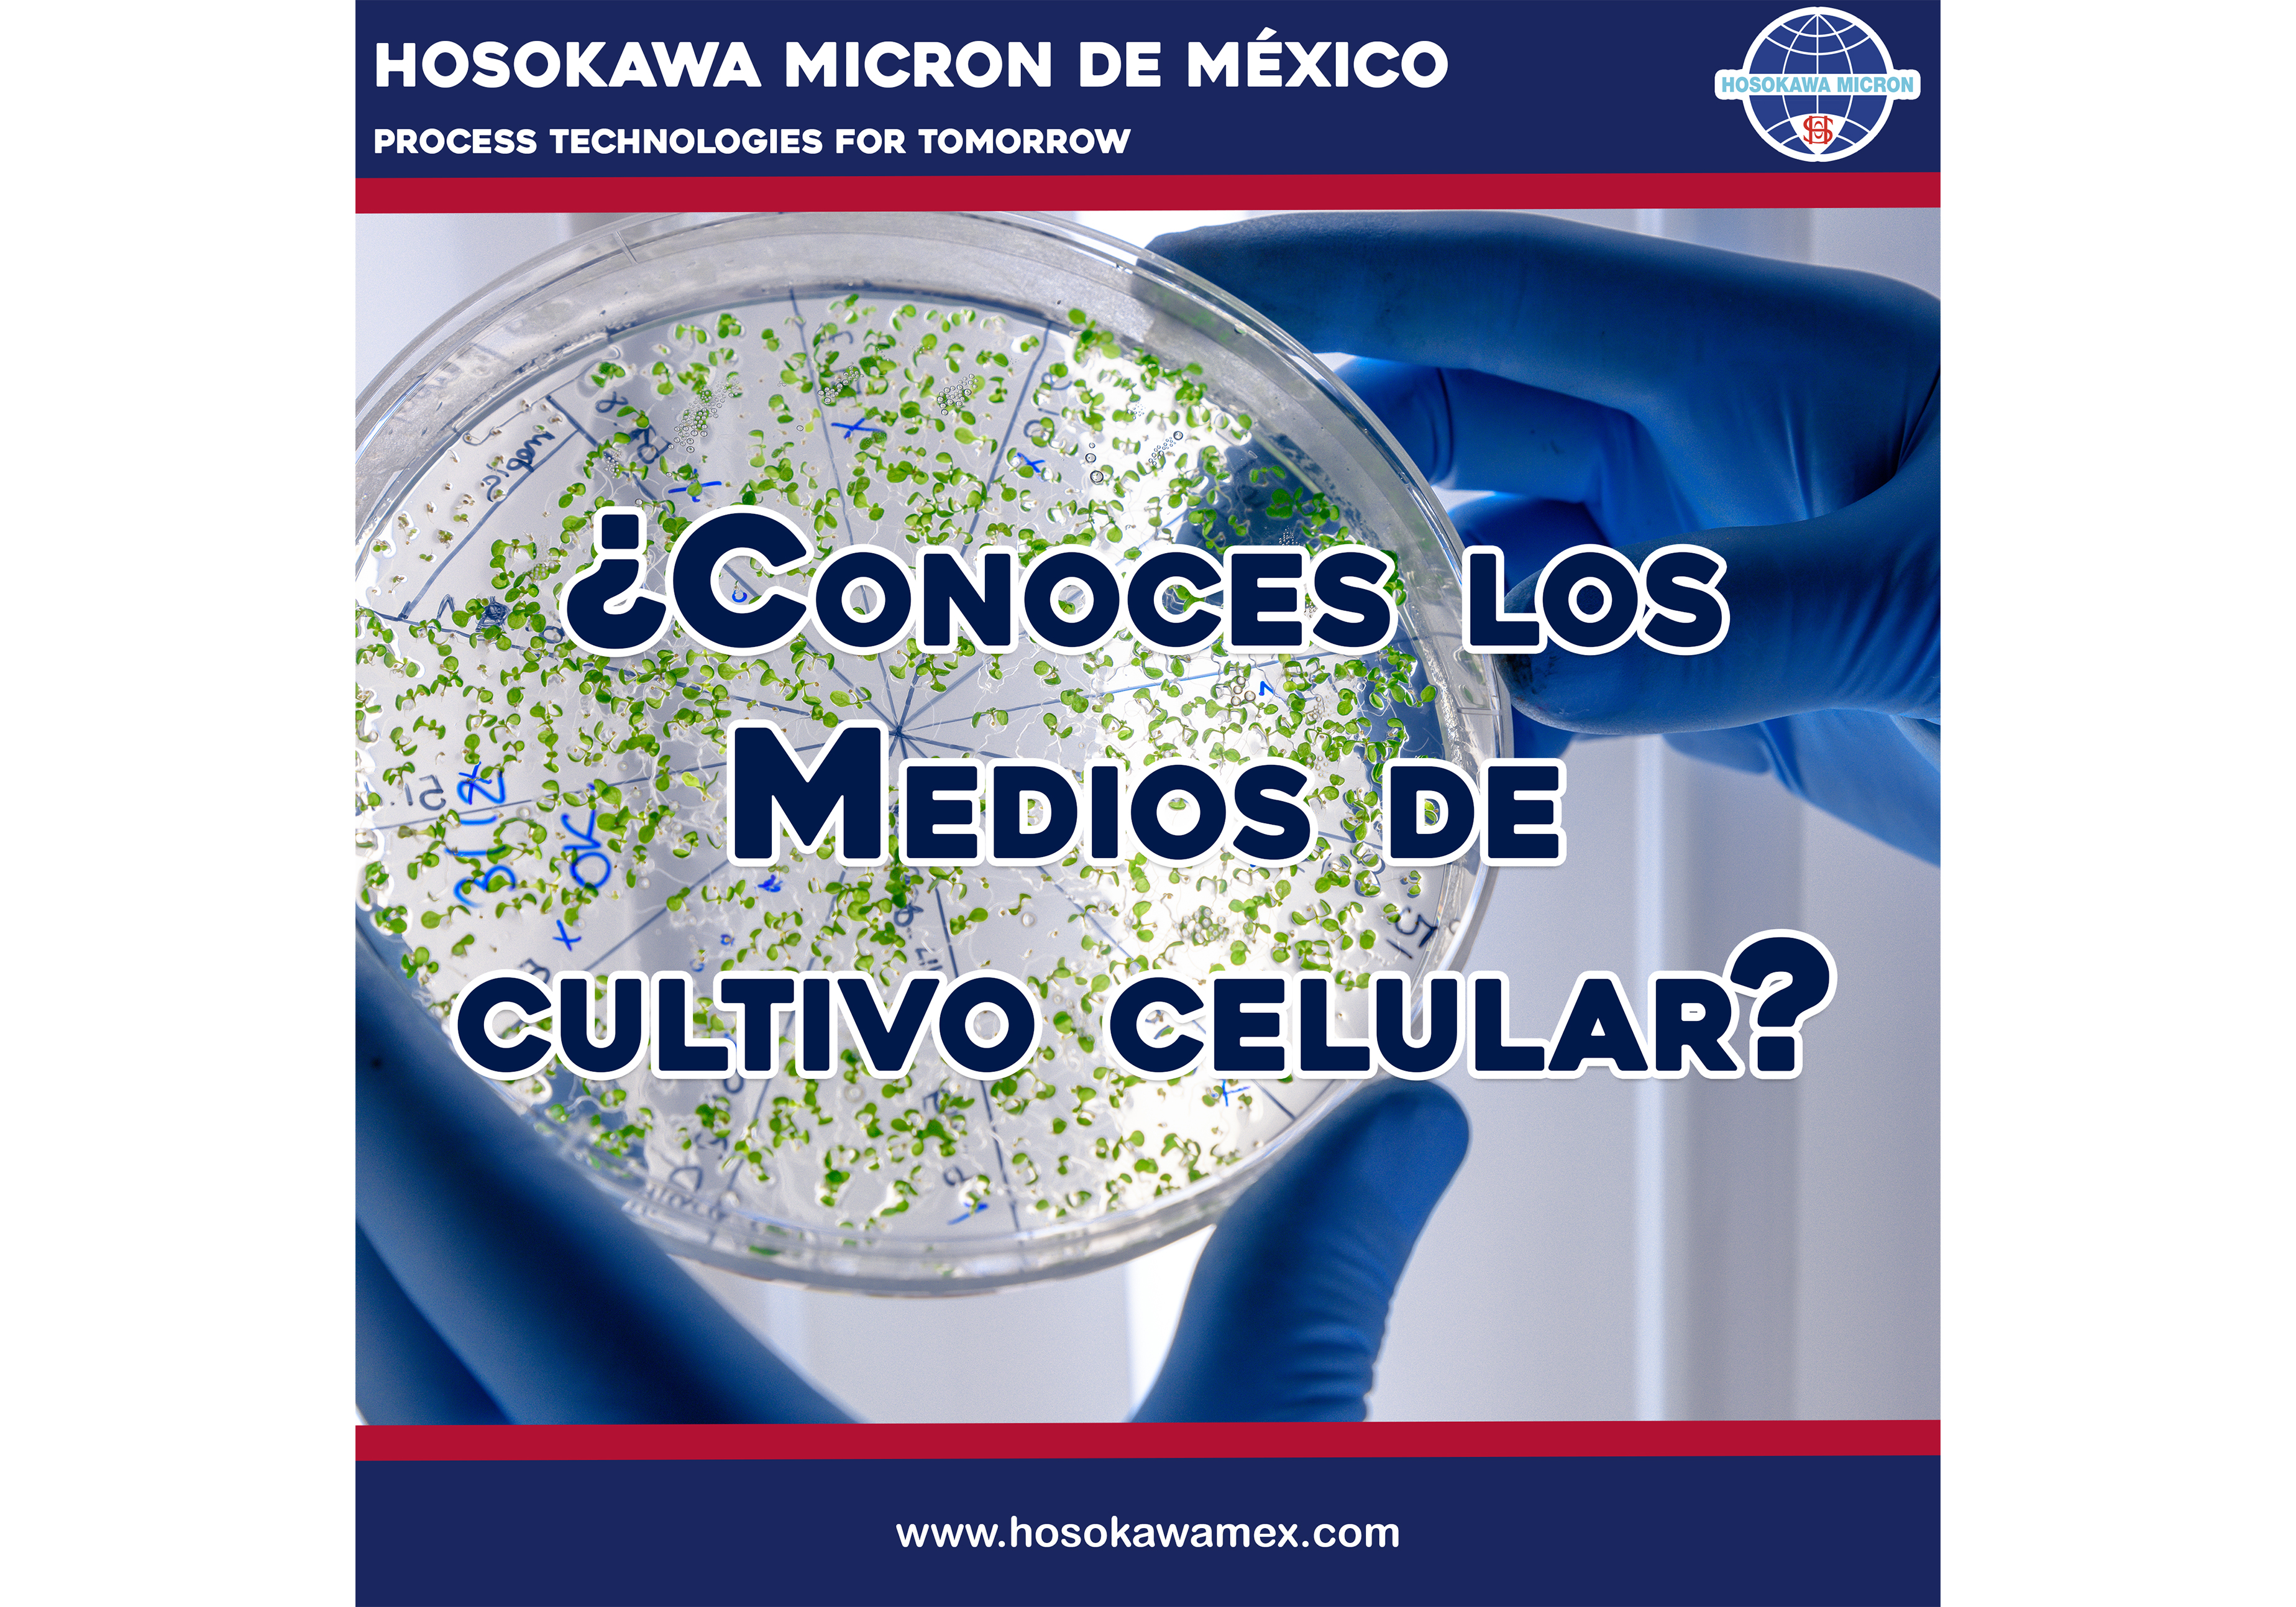
hosokawa_conoces-los-medios-de-cultivo-celular.jpg

Procesamiento de polvo para el tratamiento de medios de cultivo celular.

Probablemente haya visto imágenes de cientificos que utilizan cajas de Petri para cultivar microorganismos o ha visto enfermeras en hospitales colocando la sangre de un paciente en un tubo de ensaye para ver si hay microorganismos que causan infecciones en el torrente sanguineo de un paciente. El sustrato en las cajas de Petri son medios de cultivo celular que también se conocen como medios de crecimiento. En esencia, los medios de cultivo celular son componentes básicos para el crecimiento de microorganismos. Los medios de cultivo celular son una mezcla de muchos ingredientes. Basados en la aplicación o los objetivos científicos al tratar de cultivar una cepa particular de microorganismos, el medio de cultivo tendrá una combinación de una fuente de carbono, como la glucosa, varios tipos de nitratos o sales, aminoácidos y muchos más ingredientes.
Hosokawa Micron es líder en el suministro de sistemas de procesamiento de polvo para el tratamiento de medios de cultivo celular. La mayoría de las empresas utilizan tres pasos en el procesamiento y/o molienda de medios de cultivo celular.
Todos los ingredientes se mezclan previamente utilizando un Mezclador Cónico de tornillo Nauta®.
La mezcla se muele utilizando un Molino de pines Mikro® UMP al tamaño apropiado (generalmente en un rango entre 75 - 250 µm)
Finalmente el material molido es mezclado en un Nauta® para asegurar una mezcla homogénea.